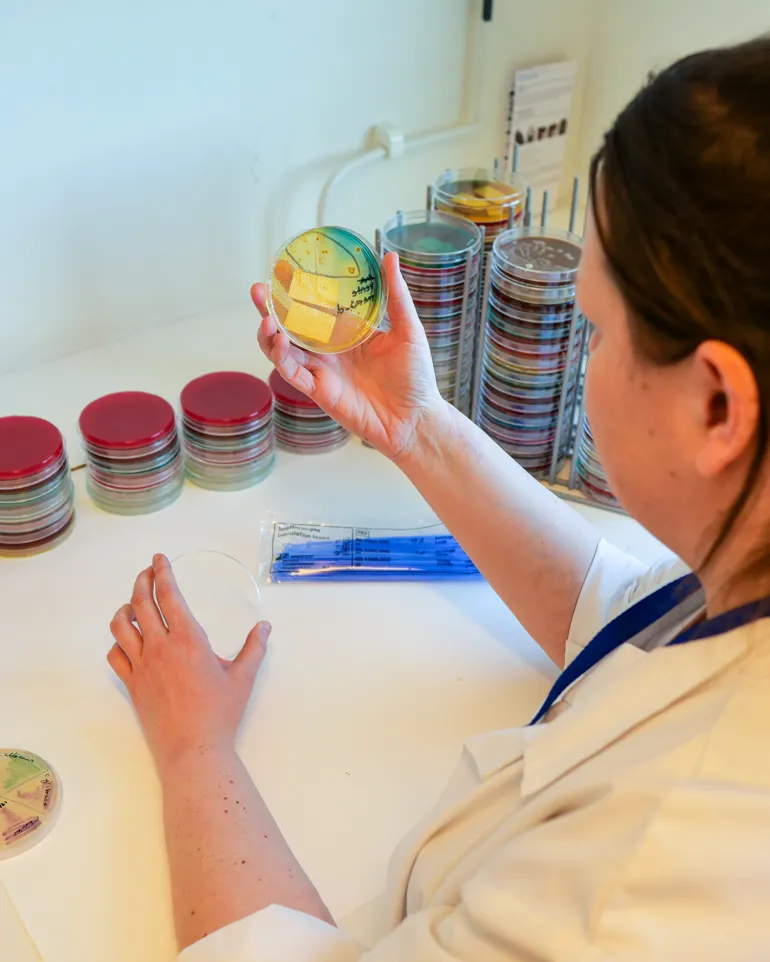

Seksjon for bakteriologi
Seksjon for bakteriologi har ansvar for avdelingens diagnostikk innen bakteriologi, mykologi, og parasittologi. Seksjonen består av to enhet lokalisert til Ullevål og Rikshospitalet.
Åpningstider & telefonummer
Kontakt
Telefon
Trykk på lenke over